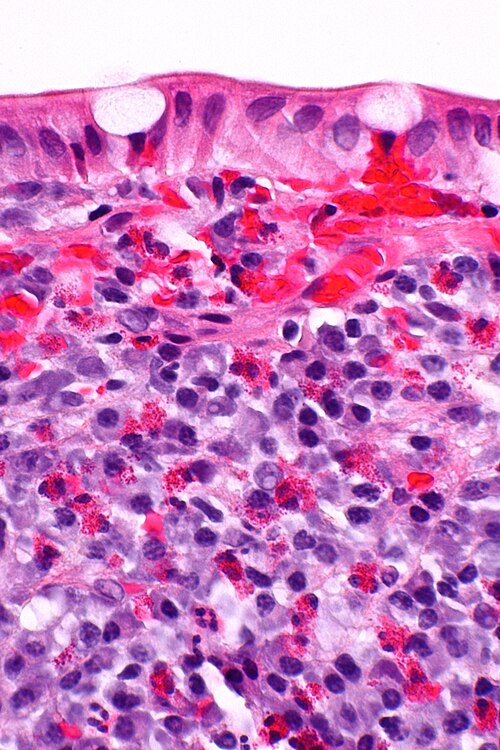

Difference between revisions of "Eosinophil"
Jump to navigation
Jump to search
| (5 intermediate revisions by the same user not shown) | |||
| Line 1: | Line 1: | ||
[[Image:Eosinophilic_colitis_--_very_high_mag.jpg|thumb|right|350px|Eosinophils in [[eosinophilic colitis]]. [[H&E stain]].]] | |||
'''Eosinophil''' is a common type of white blood cell. | '''Eosinophil''' is a common type of white blood cell. | ||
==General== | ==General== | ||
=== | ===Diseases with many eosinophils=== | ||
*Infection - esp. [[fungus|fungal]]. | *Infection - esp. [[fungus|fungal]]. | ||
*[[Drug reaction]]. | *[[Drug reaction]]. | ||
*[[Inflammatory fibroid polyp]]. | *[[Inflammatory fibroid polyp]]. | ||
*[[Churg-Strauss syndrome | *[[Eosinophilic granulomatosis with polyangiitis]] (Churg-Strauss syndrome). | ||
*[[Asthma]]. | *[[Asthma]]. | ||
*[[Kimura disease]]. | *[[Kimura disease]]. | ||
| Line 21: | Line 22: | ||
*[[Eosinophilic colitis]]. | *[[Eosinophilic colitis]]. | ||
*[[Eosinophilic gastritis]]. | *[[Eosinophilic gastritis]]. | ||
*[[Eosinophilic cholecystitis]]. | |||
*[[Pulmonary Langerhans cell histiocytosis]]. | *[[Pulmonary Langerhans cell histiocytosis]]. | ||
*[[Angiolymphoid hyperplasia with eosinophilia]] (ALHE) - skin. | *[[Angiolymphoid hyperplasia with eosinophilia]] (ALHE) - skin. | ||
*[[Eosinophilic fasciitis]]. | |||
==Microscopic== | ==Microscopic== | ||
Latest revision as of 21:02, 1 June 2023
Eosinophil is a common type of white blood cell.
General
Diseases with many eosinophils
- Infection - esp. fungal.
- Drug reaction.
- Inflammatory fibroid polyp.
- Eosinophilic granulomatosis with polyangiitis (Churg-Strauss syndrome).
- Asthma.
- Kimura disease.
- Inflammatory bowel disease.
- Langerhans cell histiocytosis.
- Hypereosinophilic syndrome (HES).[1]
- Eosinophilic myeloproliferative neoplasm.[2]
- Hodgkin lymphoma - eosinophils not malignant.
Site specific
- Eosinophilic esophagitis.
- Eosinophilic colitis.
- Eosinophilic gastritis.
- Eosinophilic cholecystitis.
- Pulmonary Langerhans cell histiocytosis.
- Angiolymphoid hyperplasia with eosinophilia (ALHE) - skin.
- Eosinophilic fasciitis.
Microscopic
Features:
- Bilobed nucleus.
- Granular eosinophilic cytoplasm.
DDx:
- Paneth cells - for intraepithelial eosinophils.
- Eosinophils have smaller (~1/2) more intensely red granules.
Images
Eosinophils in eosinophilic colitis. (WC)
See also
References
- ↑ Podjasek, JC.; Butterfield, JH. (Apr 2013). "Mortality in hypereosinophilic syndrome: 19 years of experience at Mayo Clinic with a review of the literature.". Leuk Res 37 (4): 392-5. doi:10.1016/j.leukres.2012.12.016. PMID 23332454.
- ↑ Noel, P.; Mesa, RA. (Mar 2013). "Eosinophilic myeloid neoplasms.". Curr Opin Hematol 20 (2): 157-62. doi:10.1097/MOH.0b013e32835d81bf. PMID 23385615.